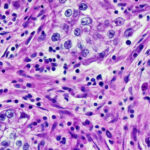

What scientists found inside Titan was not what anyone expected
For years, scientists thought Saturn’s moon Titan hid a global ocean beneath its frozen surface. A new look at Cassini […]
What scientists found inside Titan was not what anyone expected Read Post »